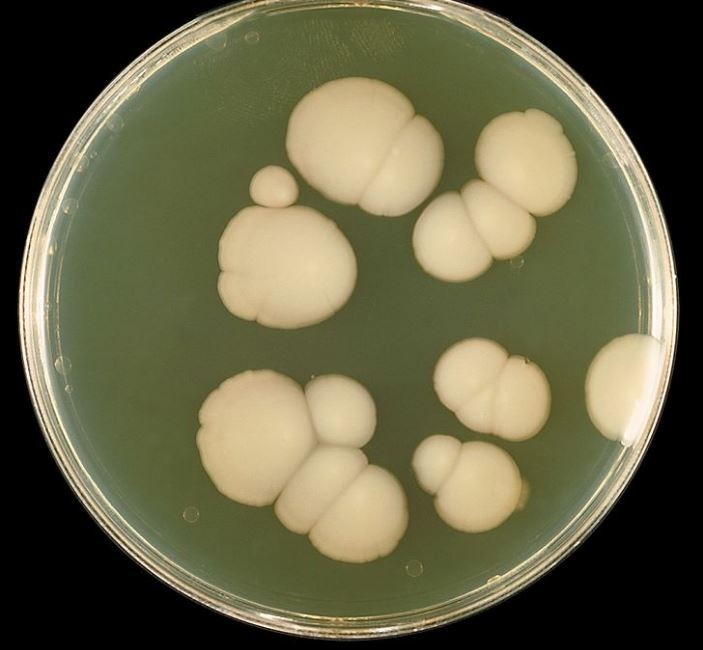

In this post you will learn how to treat candida and candidiasis infection with diet. The diet is commonly known as “the candida diet” but I’ve also listed other things you can do to help beat candida too. These are simple and natural ways to tackle this invasive disease, and I speak from personal experience here having suffered from this in the past.
IMPORTANT: If you think you are suffering from a fungal infection such as candida, you should seek professional medical advice first and foremost. The information given in this article is not intended to replace professional medical advice but to give you more information about natural ways which could help you.
This article contains some affiliate links, which means that if you decide to buy, I may receive a small commission at no extra cost to you. As an Amazon Associate, I earn from qualifying purchases. This helps me keep The Creative Choice growing and free for readers. I appreciate your support. For more information, see our Affiliate Disclosure.
But before we get into all that, here’s some background on candida infections.

Candida albicans
Candida And Candidiasis? – What Are They?
I have always been a healthy person, who rarely suffers from debilitating illness. I have never yet spent a night in hospital and only visit my doctor rarely. But a few years ago I developed a strange rash on my arms that would seemingly come and go at random. I could be fine one minute and the next, my arms would be covered with small red dots which would take between 2 and 4 hours to disappear.
 I changed my washing powder thinking I had developed sensitive skin but the rash then started appearing on my legs too, and one time when I was at the beach, my entire body broke out in the red rash and I spent the entire day under a towel. I was also extremely tired which was unusual for me as I always have lots of energy.
I changed my washing powder thinking I had developed sensitive skin but the rash then started appearing on my legs too, and one time when I was at the beach, my entire body broke out in the red rash and I spent the entire day under a towel. I was also extremely tired which was unusual for me as I always have lots of energy.
I consulted the doctor who did some tests to rule out more serious illnesses and in the absence of anything else, he put it all down to stress.
I was not so easily put off however and I began researching online some of the symptoms that I was experiencing, and later found out that I had an intestinal yeast infection known as candida or candidiasis, so I set about finding out how to treat candidiasis using natural methods.
What I discovered along the way though, was that I was not alone, and that many other people were suffering from a variety of symptoms such as:
- strange rashes like the ones I had suffered
- tiredness
- irritability
- aches and pains
but all were told by their doctors that there was nothing wrong with them.
One of the problems that I and others faced, is that because the symptoms could be related to many different conditions, and there are not many doctors who even acknowledge the existence of candida, these patients are often misdiagnosed or their diagnosis is missed! So people turn to online advice and support groups for help.
I did indeed find help and after following a diet and natural health plan for a few months, my rashes stopped, and I returned to full health.
So read on if you are suffering from similar symptoms and can’t find help elsewhere.
I should point out straight away that I am NOT a doctor or qualified in the medical profession and you should always seek appropriate medical advice for the conditions that I describe. However, as an ex-fellow-sufferer, I give you this information in the hope that with a few diet and lifestyle changes, you will find the help you need.
Let’s start with a bit of background
What is Candida and Candidiasis?
Candida albicans is a naturally occurring fungal organism that lives mostly in human colons and is therefore a commensal organism part of the natural microflora in the gut, like the ‘good’ bacteria we need to digest food, that is now common in popular breakfast drinks.
Candida albicans is normally a ‘harmless inhabitant of mucocutaneous tissues’ according to Paul L Fidel Jr in his book “The Medical Importance of the Normal Microflora“, but can quickly turn into a highly pathogenic organism if not kept in check by the person’s usual defense mechanisms such as other bacteria in the gut. Pathogenic means that it is capable of causing illness and infection.
In healthy individuals, it exists in the body in balance with other organisms, but if the host defenses are weakened either by disease, poor diet, the overuse of antibiotics (which can kill bacteria but leave fungal organisms intact), candida albicans can grow and become over abundant in the gut.
A proliferate Candida albicans organism spreads like a weed, sprouting long thin tendrils that can burrow into the host’s intestinal walls. It produces spores like other fungal organisms. The problem with this is that it can then spread from the gut and leak into other areas of the body. This can then be said to be invasive. Some people call it ‘leaky gut’.
Candida albicans can transform and become resistant to antibiotics and anti-fungal treatments so it becomes more difficult to eradicate.
If the spores get into the blood stream, they can be carried to other organs where the warm and moist conditions become perfect for the fungus to grow. Many women get vaginal thrush, especially after taking a course of antibiotics. Thrush can usually be treated easily with topical or oral medication, however if candida becomes invasive in other parts of the body, it is much harder to treat.
Fungal infections in different areas of your body can lead to the host of symptoms that sufferers of candida infections describe and it is frustrating when your doctor does test after test and they all come up negative.
What Are The Common Symptoms of a Candida Infection?
 If you have a candida infection, if can affect you in any number of ways, depending on where the fungus has grown in your body. Depending on the severity of the infection and the resilience of the pathogen, sufferers can experience some or all of the following symptoms:
If you have a candida infection, if can affect you in any number of ways, depending on where the fungus has grown in your body. Depending on the severity of the infection and the resilience of the pathogen, sufferers can experience some or all of the following symptoms:
- abdominal bloating
- arrythmias (irregular heart beat)
- asthma
- colds and flu-like symptoms
- dark circles under the eyes
- dental problems
- diarrhoea and/or constipation
- difficulty in concentrating
- digestive disorders
- dry mouth
- ear infections
- excessive flatulence or gas build-up
- gluten intolerance
- hair and nails becoming dry and brittle
- hay fever
- headaches
- increased mucous production
- increased sugar cravings
- increased temperatures/fevers
 intolerance to alcohol or strong odours
intolerance to alcohol or strong odours- irritability or anger issues
- joint aches and pains
- light headed feelings or feeling faint
- feelings of depression
- poor circulation resulting in numbness in the fingers and toes
- prolonged or constant tiredness or fatigue
- restless legs
- sexual dysfunction
- shortness of breath
- short-term memory loss
- sinus irritability of problems
- sleep disruption
- tense or tight neck and shoulder
- unusual or unexplained rashes
- white coating on the tongue
These are some of the most common symptoms reported but there may be others. And the problem of getting a correct diagnosis is exacerbated because many of these symptoms have differential diagnoses too, meaning they could indicate other diseases or infections as well. I experienced a strange rash all over my body that would just appear at the most inopportune moments, and I also felt fatigued and bloated most of the time.
Diagnostic Tests
 When you go to the doctor, they make a diagnosis by taking a patient history, physically examining you and considering your symptoms.
When you go to the doctor, they make a diagnosis by taking a patient history, physically examining you and considering your symptoms.
The definitive test for any infection, be it bacterial, viral or fungal, is to take a sample and to see if you can grow the organism in a culture. This means that a diagnosis can be specific, identifying the organism causing the infection, but it takes time to grow the culture.
This type of diagnostic test usually requires a stool or saliva sample since candida is usually active in your colon or mouth. And you have to convince the doctor to agree to the test in the first place.
Can You Test Yourself?
Some websites claim that you can do a simple spittle test to if you think you have candidiasis. The jury is out on whether this is really an effective test as it can create false positive results because there can be a number of other reasons for the effects seen.
The test involves simply creating some saliva in your mouth and carefully spitting it into a glass of water. You leave the glass after about 20 minutes and then come examine it to see if there are any signs of candida.
Indicative signs would be:
- thread-like ‘strings’ coming down from the saliva into the water
- opaque specks of saliva that are suspended in the water
- cloudy looking saliva sitting at the bottom of the glass
The test can be an indication of a candida infection, but if you are seriously worried that you have candidiasis, you should see a healthcare professional for more reliable results.
The reliability of the spittle test is disputed but it can be one more clue to discovering the problem.
Why Do People Develop Candidiasis?
The thing to remember about candidiasis is that the organism responsible for it is already in your gut. We all have candida in us already. It is not an infection that you catch from someone else like a cold or flu. You are already harbouring the yeast that attacks you but it usually only changes from a benign organism into an opportunistic pathogen when your immune system is compromised by other factors.
There are a number of reasons why people can develop candidiasis but 2 of the main ones are usually to do with:
- an extended course of antibiotics, or
- extended periods of stress.

Antibiotics can upset the natural flora of the gut, killing the ‘good’ bacteria that usually keeps the candida at bay. Without the inhibiting effects of the good bacteria, fungal organisms can thrive. If people are treated with one, two or even three courses of antibiotics to treat a particularly resistant bacterial infection, the result can be that the bacterial infection is eventually treated, but at the expense of a fungal one.
This is often the case with immunocompromised patients in hospital if they are given high doses of antibiotics from different antibioitic categories and fungal infections then need drugs such as fluconazole or strong drugs like amphotericin B, to treat them.
Excessive stress can also play havoc with your health. A certain amount of stress is important in everyday life because it can keep you at the top of your game, but too much stress can affect not only your mental state but cause many physical problems too.
 Other reasons that people develop candida include:
Other reasons that people develop candida include:
- High sugar diet and/or poor nutrition – candida is a yeast and feeds on sugar
- Certain contraceptives can increase yeast growth – these include increased estrogen levels common in many contraceptive pills, and copper intrauterine devices (IUDs). Research has linked both of these to increased yeast growth.
- Old-style mercury fillings can exacerbate fungal infections such as candida by weakening the bodies own immune systems and since mercury can be poisonous to the body, it can exacerbate the symptoms of candida due to its neurotoxic effects.
- Hormonal imbalances such as those related to menstruation or pregnancy.
- Uncontrolled diabetes – if you suffer from diabetes, you can have higher blood sugar levels than people who don’t have diabetes, and you may have a weakened immune system. For these 2 reasons, people who suffer from diabetes can have an increased incidence of fungal infections.
- Exposure to certain chemicals which are designed to aid health such as chlorine and fluoride can actually disrupt the flora in your gut, killing the good bacteria you need and letting the opportunistic yeasts thrive.
- Lack of sleep or other lifestyle choices that weaken the immune system.
- Eating processed foods or foods that are high in pollutants. This can again weaken your immune system, giving pathogenic organisms and advantage.
- Obesity can create opportunities for candida since many obese people have more folds in their skin such as around the belly and crotch areas or even under the bust area. Since fungal organisms like damp, moist conditions, these can provide a perfect habitat for them.
- Understanding the reasons you have developed an invasive candida infection can help you to prevent further infections in the future.
For me, I now understand that I had both chronic stress at the time and had taken 2 courses of antibiotics which created my problem. I have not had many courses of antibiotics in my life at all, but I had developed a resistant chest infection one winter and it took 2 courses of antibiotics to cure it. However, it also left me open to get a candida infection too.

How Can You Treat Candidiasis Naturally?
Depending on how severe your candidiasis is, you may need anti-fungal medications which in some places you can get over the counter to treat things like thrust or athlete’s foot. If your candidiasis is more systemic, you may need a prescription from your doctor.
I reiterate again here, that if think you are suffering from a candida infection, you should seek professional medical advice from your pharmacist and/or doctor first.
When I was suffering from candidiasis, the doctors could find nothing wrong with me after several tests. However, I did manage to alleviate my symptoms by tackling the problem from the inside out – by diet. I researched candida on the internet, read books and set about starving the yeast by sticking to a diet plan that was low in sugar and yeast.
The thinking behind tackling candida with diet is logical and natural – if you take away the food source from the pathogen, it will not be able to survive within your body, so effectively you are ‘starving’ the organism of enough nutrients until your natural immune system is able to take over and bring the candida back under control.
 If you then maintain a normal healthy eating plan, and avoid the situations that caused your candida in the first place, your body can maintain a healthy balance of gut microflora.
If you then maintain a normal healthy eating plan, and avoid the situations that caused your candida in the first place, your body can maintain a healthy balance of gut microflora.
This is really aimed at tackling systemic candida which has migrated from the gut into other areas of the body, but the principles should still apply for more localised infections such as oral or vaginal thrush.
I found several excellent books on the subject including information and recipes and withing 2 months, my symptoms had gone away, and I’m pleased to say, that they have not re-emerged since.
I have listed some of the resources that I found helpful at the end of this post, but have also listed some of the main principles for the diet so that you can start immediately too:
The Candia Diet
As stated above, a diet which will help reduce candida in the body is one which is:
- low in sugar
- low in yeast
- high in low-carb vegetables
- allows animal proteins and some fats

You usually follow the diet to clearse your body of the candida. You can also take some supplements (see below) in the form of vitamins, minerals and probiotics to support your own immune system as you progress.
Food Rules of the Candida diet: The ‘Can’t Eat’ List
- No sugar in any form including organic sugars, syrups and saps
- No alcohol since this is a form of sugar
- No grains or foods containing yeasts such as most breads, cake, bagels, chocolates or grain-based puddings (cake sponges etc)
- No white bread
No yeast or products containing yeast
- No pizza or pasta
- No caffeine
- No ‘moldy’ foods like blue cheeses
- No processed meats such as spam, luncheon meat, bacon, sausage
- No high-sugar fruit, dried fruit, juices since these are high in fruit sugars
- No dairy such as cheese and milk which contain sugar in the form or lactose (some cottage cheese and natural probiotic yoghurt may be allowed later in the diet)
- No beans, pulses or grains as these can be hard to digest and can negatively affect your immune system
- Avoid sugary drinks such as fruit juices, energy drinks, squashes and fizzy drinks.
This may seem like a lot of your favourite foods (I know the carbs can be difficult to cut out, and for me it was things like having no fruit and no cheese that made this more restrictive than most other nutrition plans).
However, I began to find more foods that I could eat which I had not really been aware of before then.
Hidden Sugars To Look Out For
If you are following the diet, you must avoid the above list but there are many hidden sugars in foods as well, especially in processed of prepacked ready meals so you need to read the labels on foods carefully and avoid them.
Try to eat less processed foods in general because they tend to be higher in fat, salt and sugar than homemade foods.
Hidden sugars in foods include:
- Agave nectar, syrup or sap
- Barley malt
- Sugar beet
- Brown rice syrup
- Brown Sugar
- Coconut sugar
- Date sugar
- Dextrose
- Fructose
- Fruit juice sweeteners
- High fructose Corn Syrup
- Honey
- Lactose
- Maltodextrin
- Maltose
- Maple sugar
- Maple syrup
- Molasses
- Sugar cane juice or syrup
- Powdered Sugar
The “Can Eat” List
Below is a list of general foods you can and should eat on the candida diet:
- Eggs which are a good source of protein and contain no carbs
- Vegetables especially low-carb vegetables
 Proteins such as chicken, turkey, ham, beef, lamb, venison
Proteins such as chicken, turkey, ham, beef, lamb, venison- Fish such as salmon is good, but be careful as some fish can contain toxins such as mercury
- A small amount of whole nuts, seeds and pulses
- Small amounts of types of rye bread or soda bread
- Rice crackers
- Butter, and or full-fat cream are acceptable on the diet as they only contain small amounts of lactose.
- Low-sugar fruits like blueberries, blackberries, raspberries and strawberries can be eaten but sparingly
- Drink lots of water.
You really do have to go back to first principles when following the candida diet and learn to cook using the foods you can eat above. But this will be a much healthier diet than many of us in the West are used to following.
I suggest also that you allow yourself some healthy treats from time to time otherwise you will find it more difficult to stick to the plan and you could risk a big blow out or coming off the plan completely.
Choose healthy snacks, though and read the labels closely. There are many more gluten-free and reduced sugar snacks on the market nowadays to help you.
I also found a no-yeast soda bread that I used to eat sparingly which, although not stricly on the plan, worked for me.
 How Long Do I Need To Stay On The Plan?
How Long Do I Need To Stay On The Plan?
This is a bit like the ‘piece of string’ question because it will depend on:
- how severe your candidiasis is
- the condition of your immune system, and
- how strictly you stick to the diet.
Some people can see progress in a week or two, others take a few months.
I personally stuck to the diet for about 6 weeks and noticed a big difference in that time. I then gradually reintroduced certain foods like rye breads with no yeast in them, a wider selection of vegetables as well as more fruits. After 8-10 weeks I was able to go back to a normal healthy eating plan but I was much more aware of the sugar in my diet.
And, I lost weight too which was a pleasant bonus.
Will The Diet Cure My Candidiasis?
This is the million-dollar question and one that really only a double-blind, placebo-controlled trial in humans could really answer and there are precious few of these around. With many of the mainstream medical profession not really believing that systemic candidiasis causes many of the symptoms I’ve described, we will have to wait a long time for anyone to do them. But this does not necessarily mean that the diet doesn’t work.
The medical profession, just like other things in life are governed by finances and the need to make a profit. Large pharmaceutical companies invest in trials if they think there is a profit in it for them in the long run. Researching drugs and getting them approved and to market is costly and takes years. There is no incentive for the pharmaceutical companies to conduct candida diet trials to test a natural diet and therefore they will never to done.
 Whilst controlled-trial evidence is lacking however, there is a lot of anecdotal evidence from sufferers like myself that suggests that sticking to the diet will help reduce the growth of candida in the body, thus giving your own immune system a chance to recover control and return to balance.
Whilst controlled-trial evidence is lacking however, there is a lot of anecdotal evidence from sufferers like myself that suggests that sticking to the diet will help reduce the growth of candida in the body, thus giving your own immune system a chance to recover control and return to balance.
Anecdotal evidence is that derived from people’s experiences of doing something or not doing something and then reporting to friends and family etc on their findings. Think of your mother telling you that peppermint tea is a good digestive or to rub arinca on bruises. No one has done expensive double-blind, placebo-controlled trials on these things, but it you try it, you can find it works for you.
Some doctors suggest that following the candida diet just makes people feel healthier generally because they cut out sugars and yeast which then leads them naturally to feel better. This could be the case, and to be honest, it didn’t really matter to me why it worked, I just know that it did for me.
With the candida diet, the changes you will need to make to your diet are drastic in some circumstances – especially if you are used to eating a lot of sugary foods, but this is likely one of the reasons you developed the condition in the first place. Our grandparents and their grandparents diet was very low in sugar, and it is only in the last 100-150 years that we have increased our sugar intake almost exponentially. No wonder that we are now facing an obesity crisis in the Western world.
Whatever conclusions you draw from your own experiences are fine. I am just giving you my honest opinion that before I went on the diet I was fatigued and prone to unexpected, unexplained rashes. After 2 months on the diet, I felt better, the rashes disappeared and I’d also lost over a stone in weight. So to me, the diet was worth it and it helped. But you will need to decide for yourself.
And for the record, I also like peppermint tea as a digestive and use arnica on my family’s bruises.
What Else Can You Do To Help?
I said at the beginning of this article that stress was one of the main causes of candidiasis so anything you can do to reduce your stress levels can help with your recovery. I understand that life can be a crazy roller coaster at times, but you really are in charge of your own destiny as the other posts on this site will tell you.
Try to make more time for yourself. You are important and deserve it. As a busy single, working mum, I know that time is precious but if you don’t take time for yourself, illness is inevitable and then you can care for no one!

To take better care of your own health, you could:
- Try to relax more – meditation is a great way to calm you mind, reduce stress and get in touch with your inner self
- Exercise regularly doing something you like (swim, walk, run, dance, gym, gardening)
- Get plenty of sleep
- Drink more water
- Stick to a healthy and nutritional eating plan which supports your immune system
- Get outside more and enjoy the outdoors and fresh air
- Listen to affirmations or guided meditations to help you sleep, relax or calm your mind.
What To Do After Your Candidiasis is Under Control
 Once you feel that your candidiasis has been brought back under control and that the candida now exists within you back in its commensal rather than pathogenic form, you should consider reverting to a healthy eating plan that can rebuild your natural gut flora and then maintain that.
Once you feel that your candidiasis has been brought back under control and that the candida now exists within you back in its commensal rather than pathogenic form, you should consider reverting to a healthy eating plan that can rebuild your natural gut flora and then maintain that.
Keeping a healthy gut flora is important for many reasons, and so adding things back into your diet will be necessary going forward.
More Information and Resources To Help You
As a former candida sufferer, I can honestly say that it made my life a misery, but there is hope and help out there if you get the information and help you need.
I am now well and much more conscious of what I eat and how stress affects me, so I actively try to reduce my stress levels and feel much better for it. I also suffered from bouts of eczema which again were stress-activated and which I have cleared up when I reduced my stress levels. But that’s for another article.
This site is about creating your own life and being healthy comes into that. However, it is not a site dedicated to candida although there are many sites out there that are, where you can find much more information.
When I realised I had candida, I wanted to know as much as I could about it and read as many books and articles as I could. I’ve listed below some of the things that helped me, which you can get on Amazon or from other independent retailers, too.
The Candida Diet Solution: How you can cure candida in 4 simple steps
In the spirit of helping fellow sufferers, I have therefore listed some of the dedicated candida websites below to help you in your search for a cure too.
Candida-Specific Websites
I hope that you find the information and advice you need to help bring you back to full health.
Wishing you lots of health and happiness.
RELATED ARTICLES
Hope versus fear: help in difficult times
How to do affirmations that work: my top ten tips
Ways to raise your vibrational frequency
Ready, steady, go SLOW: the law of attraction and meditation





Hi Gail, thanks for the really interesting article. This horrible infection is the reason I avoid antibiotics if I possibly can. I find they wreak havoc with the bacteria in my gut. If I do have to have antibiotics (like a few weeks ago for a persistent chest infection) then I increase my intake of yogurt and take probiotics. Up to now that’s all I’ve done. Sometimes it works and sometimes it doesn’t.
This is excellent information to have and I thank you for it. I’ll be bookmarking this page. I guess some people are just more susceptible to this than others. Most people think I’m mad when I say I’d rather not take antibiotics when I’m sick. For me I need to weigh up the effect they have on my body vs the problem I’m experiencing. Thank you
Hi Melissa. Thanks for reading my article and leaving a comment. Sorry to hear that you have had an infection but glad you have found a way to keep your natural balance using other methods than antibiotics. I think that too many people turn to antibiotics for simple infections and they not only risk upsetting their gut bacteria, but overuse of antibiotics can also increase antibiotic resistance too. I totally agree with you about not taking antibiotics when you don’t really need them because the body is a wonderful thing and given the right diet, exercise and mental attitude, your body can repair and heal itself.
Wishing you lots of health and happiness.
I recently purchased the book you mentioned “The Candida Diet.” As you mentioned it is a cut of pretty much all things food that I love. lol But it’s worth it when it comes to healing the body and starving the candida out. Did you experience any side effects from the candida dying off? I’ve read so much from people that had bad side effects and was curious about your experience before I started my cleanse.
Hi Jennifer. Thanks for reading and leaving a comment. I’m sorry to hear that you have to go on the diet as it really is restrictive although I can honestly say I did feel a lot better (and was a lot slimmer) after doing it. I know there is a lot of information about yeast die-off online but I didn’t really see it myself. Either that, or because my initial symptoms were the rashes and fatigue anyway, I may just have not recognised the die-off symptoms at the time. I think that these are transient though and don’t usually last more than a week, so it’s worth it because you will feel much better after your cleanse.
I also was very conscious about my stress levels and did everything I could to reduce stresses in my life whilst on the diet and I know that it really helped me too. I’ve been conscious of how stress affects me ever since so I’d recommend either meditation or massages or just doing something for yourself too.
Hello Gail. Another fantastic article and everything you shared Is 100% true. I to suffered from it and Drs ointments never worked I researched and researched it and found what to do the biggest thing I did was change my diet and the BIG thing sugar. People don’t realize a lot of problems as you shared come from a poor stomach.
Thank you so much,
David
Hi David. Sorry to hear that you suffered with this as well but very glad to know that you got it sorted out in the end. I have a great respect for doctors and the medical profession, but having worked in medical education for a long time, I also know that the money for education goes to the drugs that make the most profits, so holistic things are often ignored when they have so many benefits. Diet is one of them because it affects so many illnesses. Here’s to your ongoing health and happiness.
Wow! Very thorough and informative article! So much info to take in, but well worth the read. I saved it to Pinterest and shared on Google also.
Is it possible, in a healthy manner, to keep such a restrictive diet—if you’re vegan? That would mean no eggs, meat or butter. Thoughts?
Hi Freya. Thanks for reading the post and I’m glad you got to the end! 🙂 I know there is a lot of info here and if you are suffering from this condition, then I’d advise anyone to keep researching and find out as much as they can.
I think that being a vegan may be a challenge but it’s not impossible and there are sites out there that cater for that too. Have a look at: https://www.nutriplanet.org/2016/09/vegan-candida-diet which is very specific and full of great information. I think you just need to be prepared to spend time making and preparing food, but that’ a good thing. Convenience foods are really a short-term gain.
This makes total sense to me. I am a believer that when you give your body good nutrition and less sugar and processed foods, it will take care of itself. A few years ago I eliminated sugar, all grains, and most root veggies from my diet. I ended up losing 60 pounds (which I needed to lose) but more importantly, I am so much healthier now. My doctor says I’m in excellent health. And I haven’t had so much as a cold since losing the weight.
Hi Wendy. Thanks for reading and leaving your thoughts. Great inspiration to hear of your success. Food is such an important part of our health and yet were really don’t take the time to understand it as much as we should. So pleased that you are in good shape now. All the best. Gail